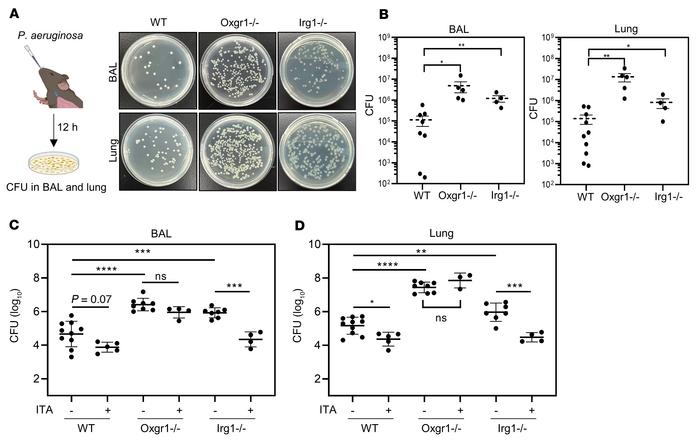

Abstract
Pathogens and inflammatory conditions rapidly induce the expression of immune-responsive gene 1 (IRG1) in cells of myeloid lineage. IRG1 encodes an aconitate decarboxylase (ACOD1) that produces the immunomodulatory metabolite itaconate (ITA). In addition to rapid intracellular accumulation, ITA is also secreted from the cell, but whether secreted ITA functions as a signaling molecule is unclear. Here, we identified ITA as an orthosteric agonist of the GPCR OXGR1, with an EC50 of approximately 0.3 mM, which was in the same range as the physiological concentration of extracellular ITA upon macrophage activation. ITA activated OXGR1 to induce Ca2+ mobilization, ERK phosphorylation, and endocytosis of the receptor. In a mouse model of pulmonary infection with bacterial Pseudomonas aeruginosa, ITA stimulated Oxgr1-dependent mucus secretion and transport in respiratory epithelium, the primary innate defense mechanism of the airway. Our study thus identifies ITA as a bona fide ligand for OXGR1 and the ITA/OXGR1 paracrine signaling pathway during the pulmonary innate immune response.
Authors
Yi-Rong Zeng, Jun-Bin Song, Dezheng Wang, Zi-Xuan Huang, Cheng Zhang, Yi-Ping Sun, Gang Shu, Yue Xiong, Kun-Liang Guan, Dan Ye, Pu Wang
Figure 5
Depletion of either Oxgr1 or Irg1 disrupts the clearance of respiratory bacteria.



Copyright © 2026 American Society for Clinical Investigation
ISSN: 0021-9738 (print), 1558-8238 (online)